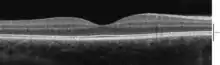

Optical coherence tomography
Optical coherence tomography (OCT) is an imaging technique that uses low-coherence light to capture micrometer-resolution, two- and three-dimensional images from within optical scattering media (e.g., biological tissue). It is used for medical imaging and industrial nondestructive testing (NDT). Optical coherence tomography is based on low-coherence interferometry, typically employing near-infrared light. The use of relatively long wavelength light allows it to penetrate into the scattering medium. Confocal microscopy, another optical technique, typically penetrates less deeply into the sample but with higher resolution.
| Optical coherence tomography | |
|---|---|
![]() Optical coherence tomography (OCT) image of a sarcoma | |
| MeSH | D041623 |
| OPS-301 code | 3-300 |
Depending on the properties of the light source (superluminescent diodes, ultrashort pulsed lasers, and supercontinuum lasers have been employed), optical coherence tomography has achieved sub-micrometer resolution (with very wide-spectrum sources emitting over a ~100 nm wavelength range).
Optical coherence tomography is one of a class of optical tomographic techniques. Commercially available optical coherence tomography systems are employed in diverse applications, including art conservation and diagnostic medicine, notably in ophthalmology and optometry where it can be used to obtain detailed images from within the retina. Recently, it has also begun to be used in interventional cardiology to help diagnose coronary artery disease,[1] and in dermatology to improve diagnosis.[2] A relatively recent implementation of optical coherence tomography, frequency-domain optical coherence tomography, provides advantages in the signal-to-noise ratio provided, thus permitting faster signal acquisition. OCT is not the same as Optical coherence microscopy (OCM), which "is a microscopic incarnation of optical coherence tomography (OCT)"[3] that can be used for 3D imaging reconstruction through intrinsic contrasting of back-scattered (coherent) light.[4]
Introduction

Starting from Adolf Fercher and colleagues’ work on low-, partial coherence or white-light interferometry for in vivo ocular eye measurements[5][6] in Vienna in the 1980s, imaging of biological tissue, especially of the human eye, was investigated in parallel by multiple groups worldwide. A first two-dimensional in vivo depiction of a human eye fundus along a horizontal meridian based on white light interferometric depth scans was presented at the ICO-15 SAT conference in 1990.[7] Further developed in 1990 by Naohiro Tanno,[8][9] then a professor at Yamagata University it was referred to as heterodyne reflectance tomography, and in particular since 1991 by Huang et al., in Prof. James Fujimoto laboratory at Massachusetts Institute of Technology,[10] who successfully coined the term “optical coherence tomography”. Since then, OCT with micrometer resolution and cross-sectional imaging capabilities has become a prominent biomedical tissue-imaging technique that continuously picked up new technical capabilities starting from early electronic signal detection, via utilisation of broadband lasers and linear pixel arrays to ultrafast tuneable lasers to expand its performance and sensitivity envelope.
It is particularly suited to ophthalmic applications and other tissue imaging requiring micrometer resolution and millimeter penetration depth.[11] First in vivo OCT images – displaying retinal structures – were published in 1993 and first endoscopic images in 1997.[12][13] OCT has also been used for various art conservation projects, where it is used to analyze different layers in a painting. OCT has interesting advantages over other medical imaging systems. Medical ultrasonography, magnetic resonance imaging (MRI), confocal microscopy, and OCT are differently suited to morphological tissue imaging: while the first two have whole body but low resolution imaging capability (typically a fraction of a millimeter), the third one can provide images with resolutions well below 1 micrometer (i.e. sub-cellular), between 0 and 100 micrometers in depth, and the fourth can probe as deep as 500 micrometers, but with a lower (i.e. architectural) resolution (around 10 micrometers in lateral and a few micrometers in depth in ophthalmology, for instance, and 20 micrometers in lateral in endoscopy).[14][15]
OCT is based on low-coherence interferometry.[16][17][6] In conventional interferometry with long coherence length (i.e., laser interferometry), interference of light occurs over a distance of meters. In OCT, this interference is shortened to a distance of micrometers, owing to the use of broad-bandwidth light sources (i.e., sources that emit light over a broad range of frequencies). Light with broad bandwidths can be generated by using superluminescent diodes or lasers with extremely short pulses (femtosecond lasers). White light is an example of a broadband source with lower power.
Light in an OCT system is broken into two arms – a sample arm (containing the item of interest) and a reference arm (usually a mirror). The combination of reflected light from the sample arm and reference light from the reference arm gives rise to an interference pattern, but only if light from both arms have traveled the "same" optical distance ("same" meaning a difference of less than a coherence length). By scanning the mirror in the reference arm, a reflectivity profile of the sample can be obtained (this is time domain OCT). Areas of the sample that reflect back a lot of light will create greater interference than areas that don't. Any light that is outside the short coherence length will not interfere.[18] This reflectivity profile, called an A-scan, contains information about the spatial dimensions and location of structures within the item of interest. A cross-sectional tomogram (B-scan) may be achieved by laterally combining a series of these axial depth scans (A-scan). A face imaging at an acquired depth is possible depending on the imaging engine used.
Layperson's explanation

Optical coherence tomography (OCT) is a technique for obtaining sub-surface images of translucent or opaque materials at a resolution equivalent to a low-power microscope. It is effectively ‘optical ultrasound’, imaging reflections from within tissue to provide cross-sectional images.[19]
OCT has attracted interest among the medical community because it provides tissue morphology imagery at much higher resolution (less than 10 μm axially and less than 20 μm laterally[20] ) than other imaging modalities such as MRI or ultrasound.
The key benefits of OCT are:
- Live sub-surface images at near-microscopic resolution
- Instant, direct imaging of tissue morphology
- No preparation of the sample or subject, no contact
- No ionizing radiation
OCT delivers high resolution because it is based on light, rather than sound or radio frequency. An optical beam is directed at the tissue, and a small portion of this light that reflects from sub-surface features is collected. Note that most light is not reflected but, rather, scatters off at large angles. In conventional imaging, this diffusely scattered light contributes background that obscures an image. However, in OCT, a technique called interferometry is used to record the optical path length of received photons allowing rejection of most photons that scatter multiple times before detection. Thus OCT can build up clear 3D images of thick samples by rejecting background signal while collecting light directly reflected from surfaces of interest.
Within the range of noninvasive three-dimensional imaging techniques that have been introduced to the medical research community, OCT as an echo technique is similar to ultrasound imaging. Other medical imaging techniques such as computerized axial tomography, magnetic resonance imaging, or positron emission tomography do not use the echo-location principle.[21]
The technique is limited to imaging 1 to 2 mm below the surface in biological tissue, because at greater depths the proportion of light that escapes without scattering is too small to be detected. No special preparation of a biological specimen is required, and images can be obtained ‘non-contact’ or through a transparent window or membrane. It is also important to note that the laser output from the instruments used is low – eye-safe near-infrared or visible-light [22] – and no damage to the sample is therefore likely.
Theory
The principle of OCT is white light, or low coherence, interferometry. The optical setup typically consists of an interferometer (Fig. 1, typically Michelson type) with a low coherence, broad bandwidth light source. Light is split into and recombined from reference and sample arm, respectively.
![]() Fig. 2 Typical optical setup of single point OCT. Scanning the light beam on the sample enables non-invasive cross-sectional imaging up to 3 mm in depth with micrometer resolution. |
![]() Fig. 1 Full-field OCT optical setup. Components include: super-luminescent diode (SLD), convex lens (L1), 50/50 beamsplitter (BS), camera objective (CO), CMOS-DSP camera (CAM), reference (REF), and sample (SMP). The camera functions as a two-dimensional detector array, and with the OCT technique facilitating scanning in depth, a non-invasive three dimensional imaging device is achieved. |
![]() Fig. 4 Spectral discrimination by fourier-domain OCT. Components include: low coherence source (LCS), beamsplitter (BS), reference mirror (REF), sample (SMP), diffraction grating (DG) and full-field detector (CAM) acting as a spectrometer, and digital signal processing (DSP) |
![]() Fig. 3 Spectral discrimination by swept-source OCT. Components include: swept source or tunable laser (SS), beamsplitter (BS), reference mirror (REF), sample (SMP), photodetector (PD), and digital signal processing (DSP) |
Time domain
In time domain OCT the pathlength of the reference arm is varied in time (the reference mirror is translated longitudinally). A property of low coherence interferometry is that interference, i.e. the series of dark and bright fringes, is only achieved when the path difference lies within the coherence length of the light source. This interference is called auto correlation in a symmetric interferometer (both arms have the same reflectivity), or cross-correlation in the common case. The envelope of this modulation changes as pathlength difference is varied, where the peak of the envelope corresponds to pathlength matching.
The interference of two partially coherent light beams can be expressed in terms of the source intensity, , as
where represents the interferometer beam splitting ratio, and is called the complex degree of coherence, i.e. the interference envelope and carrier dependent on reference arm scan or time delay , and whose recovery is of interest in OCT. Due to the coherence gating effect of OCT the complex degree of coherence is represented as a Gaussian function expressed as[6]
where represents the spectral width of the source in the optical frequency domain, and is the centre optical frequency of the source. In equation (2), the Gaussian envelope is amplitude modulated by an optical carrier. The peak of this envelope represents the location of the microstructure of the sample under test, with an amplitude dependent on the reflectivity of the surface. The optical carrier is due to the Doppler effect resulting from scanning one arm of the interferometer, and the frequency of this modulation is controlled by the speed of scanning. Therefore, translating one arm of the interferometer has two functions; depth scanning and a Doppler-shifted optical carrier are accomplished by pathlength variation. In OCT, the Doppler-shifted optical carrier has a frequency expressed as
where is the central optical frequency of the source, is the scanning velocity of the pathlength variation, and is the speed of light.

The axial and lateral resolutions of OCT are decoupled from one another; the former being an equivalent to the coherence length of the light source and the latter being a function of the optics. The axial resolution of OCT is defined as
where and are respectively the central wavelength and the spectral width of the light source.[23]
Frequency domain
In frequency domain OCT (FD-OCT) the broadband interference is acquired with spectrally separated detectors. Two common approaches are swept-source and spectral-domain OCT. A swept source OCT encodes the optical frequency in time with a spectrally scanning source. A spectral domain OCT uses a dispersive detector, like a grating and a linear detector array, to separate the different wavelengths. Due to the Fourier relation (Wiener–Khinchin theorem between the auto correlation and the spectral power density) the depth scan can be immediately calculated by a Fourier-transform from the acquired spectra, without movement of the reference arm.[24][25] This feature improves imaging speed dramatically, while the reduced losses during a single scan improve the signal to noise ratio proportional to the number of detection elements. The parallel detection at multiple wavelength ranges limits the scanning range, while the full spectral bandwidth sets the axial resolution.[26]
Spatially encoded
Spatially encoded frequency domain OCT (SEFD-OCT, spectral domain or Fourier domain OCT) extracts spectral information by distributing different optical frequencies onto a detector stripe (line-array CCD or CMOS) via a dispersive element (see Fig. 4). Thereby the information of the full depth scan can be acquired within a single exposure. However, the large signal to noise advantage of FD-OCT is reduced due to the lower dynamic range of stripe detectors with respect to single photosensitive diodes, resulting in an SNR (signal to noise ratio) advantage of ~10 dB at much higher speeds. This is not much of a problem when working at 1300 nm, however, since dynamic range is not a serious problem at this wavelength range.[23]
The drawbacks of this technology are found in a strong fall-off of the SNR, which is proportional to the distance from the zero delay and a sinc-type reduction of the depth dependent sensitivity because of limited detection linewidth. (One pixel detects a quasi-rectangular portion of an optical frequency range instead of a single frequency, the Fourier-transform leads to the sinc(z) behavior). Additionally the dispersive elements in the spectroscopic detector usually do not distribute the light equally spaced in frequency on the detector, but mostly have an inverse dependence. Therefore, the signal has to be resampled before processing, which can not take care of the difference in local (pixelwise) bandwidth, which results in further reduction of the signal quality. However, the fall-off is not a serious problem with the development of new generation CCD or photodiode array with a larger number of pixels.
Synthetic array heterodyne detection offers another approach to this problem without the need for high dispersion.
Time encoded
Time encoded frequency domain OCT (TEFD-OCT, or swept source OCT) tries to combine some of the advantages of standard TD and SEFD-OCT. Here the spectral components are not encoded by spatial separation, but they are encoded in time. The spectrum is either filtered or generated in single successive frequency steps and reconstructed before Fourier-transformation. By accommodation of a frequency scanning light source (i.e. frequency scanning laser) the optical setup (see Fig. 3) becomes simpler than SEFD, but the problem of scanning is essentially translated from the TD-OCT reference-arm into the TEFD-OCT light source. Here the advantage lies in the proven high SNR detection technology, while swept laser sources achieve very small instantaneous bandwidths (linewidths) at very high frequencies (20–200 kHz). Drawbacks are the nonlinearities in the wavelength (especially at high scanning frequencies), the broadening of the linewidth at high frequencies and a high sensitivity to movements of the scanning geometry or the sample (below the range of nanometers within successive frequency steps).
Full-field OCT

An imaging approach to temporal OCT was developed by Claude Boccara's team in 1998,[27] with an acquisition of the images without beam scanning. In this technique called full-field OCT (FF-OCT), unlike other OCT techniques that acquire cross-sections of the sample, the images are here "en-face" i.e. like images of classical microscopy: orthogonal to the light beam of illumination.[28]
More precisely, interferometric images are created by a Michelson interferometer where the path length difference is varied by a fast electric component (usually a piezo mirror in the reference arm). These images acquired by a CCD camera are combined in post-treatment (or on-line) by the phase shift interferometry method, where usually 2 or 4 images per modulation period are acquired, depending on the algorithm used.[29][30] More recently, approaches that allow rapid single-shot imaging were developed to simultaneously capture multiple phase-shifted images required for reconstruction, using single camera.[31] Single-shot time-domain OCM is limited only by the camera frame rate and available illumination.
The "en-face" tomographic images are thus produced by a wide-field illumination, ensured by the Linnik configuration of the Michelson interferometer where a microscope objective is used in both arms. Furthermore, while the temporal coherence of the source must remain low as in classical OCT (i.e. a broad spectrum), the spatial coherence must also be low to avoid parasitical interferences (i.e. a source with a large size).[32]
Line-field (confocal) OCT
Line-field confocal optical coherence tomography (LC-OCT) is an imaging technique based on the principle of time-domain OCT with line illumination using a broadband laser and line detection using a line-scan camera.[33] LC-OCT produces B-scans in real-time from multiple A-scans acquired in parallel. En face as well as three-dimensional images can also be obtained by scanning the illumination line laterally.[34][35] The focus is continuously adjusted during the scan of the sample depth, using a high numerical aperture (NA) microscope objective to image with high lateral resolution. By using a supercontinuum laser as a light source, a quasi-isotropic spatial resolution of ~ 1 µm is achieved at a central wavelength of ~ 800 nm. On the other hand, line illumination and detection, combined with the use of a high NA microscope objective, produce a confocal gate that prevents most scattered light that does not contribute to the signal from being detected by the camera. This confocal gate, which is absent in the full-field OCT technique, gives LC-OCT an advantage in terms of detection sensitivity and penetration in highly scattering media such as skin tissues.[36] So far this technique has been used mainly for skin imaging in the fields of dermatology[37][38][39][40][41][42] and cosmetology.[43]
Scanning schemes
Focusing the light beam to a point on the surface of the sample under test, and recombining the reflected light with the reference will yield an interferogram with sample information corresponding to a single A-scan (Z axis only). Scanning of the sample can be accomplished by either scanning the light on the sample, or by moving the sample under test. A linear scan will yield a two-dimensional data set corresponding to a cross-sectional image (X-Z axes scan), whereas an area scan achieves a three-dimensional data set corresponding to a volumetric image (X-Y-Z axes scan).
Single point
Systems based on single point, confocal, or flying-spot time domain OCT, must scan the sample in two lateral dimensions and reconstruct a three-dimensional image using depth information obtained by coherence-gating through an axially scanning reference arm (Fig. 2). Two-dimensional lateral scanning has been electromechanically implemented by moving the sample[25] using a translation stage, and using a novel micro-electro-mechanical system scanner.[44]
Parallel
Parallel or full field OCT using a charge-coupled device (CCD) camera has been used in which the sample is full-field illuminated and en face imaged with the CCD, hence eliminating the electromechanical lateral scan. By stepping the reference mirror and recording successive en face images a three-dimensional representation can be reconstructed. Three-dimensional OCT using a CCD camera was demonstrated in a phase-stepped technique,[45] using geometric phase shifting with a Linnik interferometer,[46] utilising a pair of CCDs and heterodyne detection,[47] and in a Linnik interferometer with an oscillating reference mirror and axial translation stage.[48] Central to the CCD approach is the necessity for either very fast CCDs or carrier generation separate to the stepping reference mirror to track the high frequency OCT carrier.
Smart detector array
A two-dimensional smart detector array, fabricated using a 2 µm complementary metal-oxide-semiconductor (CMOS) process, was used to demonstrate full-field TD-OCT.[49] Featuring an uncomplicated optical setup (Fig. 3), each pixel of the 58x58 pixel smart detector array acted as an individual photodiode and included its own hardware demodulation circuitry.
Selected applications
Optical coherence tomography is an established medical imaging technique and is used across several medical specialties including ophthalmology and cardiology, and is widely used in basic science research applications.
Ophthalmology
Ocular (or ophthalmic) OCT is used heavily by ophthalmologists and optometrists to obtain high-resolution images of the retina and anterior segment. Owing to OCT's capability to show cross-sections of tissue layers with micrometer resolution, OCT provides a straightforward method of assessing cellular organization, photoreceptor integrity,[50][51][52][53] and axonal thickness in glaucoma,[54] macular degeneration,[55] diabetic macular edema,[56] multiple sclerosis[57] and other eye diseases or systemic pathologies which have ocular signs.[58] Additionally, ophthalmologists leverage OCT to assess the vascular health of the retina via a technique called OCT angiography (OCTA).[59] In ophthalmological surgery, especially retinal surgery, an OCT can be mounted on the microscope. Such a system is called an intraoperative OCT (iOCT) and provides support during the surgery with clinical benefits.[60][61][62] Polarization-sensitive OCT was recently applied in the human retina to determine optical polarization properties of vessel walls near the optic nerve.[63]
Cardiology and intravascular applications
In the setting of cardiology, OCT is used to image coronary arteries in order to visualize vessel wall lumen morphology and microstructure at a resolution 10 times higher than other existing modalities such as intravascular ultrasounds, and x-ray angiography (intracoronary optical coherence tomography). For this type of application, approximately 1 mm in diameter fiber-optics catheters are used to access artery lumen through semi-invasive interventions such as percutaneous coronary interventions.
The first demonstration of endoscopic OCT was reported in 1997, by researchers in James Fujimoto laboratory at Massachusetts Institute of Technology, including Prof. Guillermo James Tearney and Prof. Brett Bouma.[64] The first TD-OCT imaging catheter and system was commercialized by LightLab Imaging, Inc., a company based in Massachusetts in 2006. The first FD-OCT imaging study was reported by the laboratory of Prof. Guillermo J. Tearney and Prof. Brett Bouma based at Massachusetts General Hospital in 2008.[65] Intravascular FD-OCT was first introduced in the market in 2009 by LightLab Imaging, Inc.[66] and Terumo Corporation launched a second solution for coronary artery imaging in 2012. The higher imaging speed of FD-OCT enabled the widespread adoption of this imaging technology for coronary artery imaging. It is estimated that over 100,000 FD-OCT coronary imaging cases are performed yearly, and that the market is increasing by approximately 20% every year.[67]
Intravascular OCT has been investigated for use in neurovascular applications, too, including imaging for guiding endovascular treatment of ischemic stroke and brain aneurysms.[68] Clinical use has been limited to proximal intracranial anatomy of patient with limited tortuosity, showing the potential of OCT for the imaging of neurovascular disease.[69] An intravascular OCT imaging catheter design tailored for use in tortuous neurovascular anatomy has been proposed in 2020.[70]
Further developments of intravascular OCT included the combination with other optical imaging modalities (multi-modality imaging). OCT has been combined with fluorescence molecular imaging to enhance its capability to detect molecular/functional and tissue morphological information simultaneously.[71] In a similar way, combination with near-infrared spectroscopy has been also demonstrated.
Oncology
Endoscopic OCT has been applied to the detection and diagnosis of cancer and precancerous lesions, such as Barrett's esophagus and esophageal dysplasia.[72]
Dermatology
The first use of OCT in dermatology dates back to 1997.[73] Since then, OCT has been applied to the diagnosis of various skin lesions including carcinomas.[74][75][76] However, the diagnosis of melanoma using conventional OCT is difficult, especially due to insufficient imaging resolution.[77] Emerging high-resolution OCT techniques such as LC-OCT have the potential to improve the clinical diagnostic process, allowing for the early detection of malignant skin tumors – including melanoma – and a reduction in the number of surgical excisions of benign lesions.[78] Other promising areas of application include the imaging of lesions where excisions are hazardous or impossible and the guidance of surgical interventions through identification of tumor margins.
Dentistry
Researchers in Tokyo medical and Dental University were able to detect enamel white spot lesions around and beneath the orthodontic brackets using swept source OCT.[79]
Research applications
Researchers have used OCT to produce detailed images of mice brains, through a "window" made of zirconia that has been modified to be transparent and implanted in the skull.[80] Optical coherence tomography is also applicable and increasingly used in industrial applications, such as nondestructive testing (NDT), material thickness measurements,[81] and in particular thin silicon wafers[82][83] and compound semiconductor wafers thickness measurements[84][85] surface roughness characterization, surface and cross-section imaging[86][87] and volume loss measurements. OCT systems with feedback can be used to control manufacturing processes. With high speed data acquisition,[88] and sub-micron resolution, OCT is adaptable to perform both inline and off-line.[89] Due to the high volume of produced pills, an interesting field of application is in the pharmaceutical industry to control the coating of tablets.[90] Fiber-based OCT systems are particularly adaptable to industrial environments.[91] These can access and scan interiors of hard-to-reach spaces,[92] and are able to operate in hostile environments—whether radioactive, cryogenic, or very hot.[93] Novel optical biomedical diagnostic and imaging technologies are currently being developed to solve problems in biology and medicine.[94] As of 2014, attempts have been made to use optical coherence tomography to identify root canals in teeth, specifically canal in the maxillary molar, however, there is no difference with the current methods of dental operatory microscope.[95][96] Research conducted in 2015 was successful in utilizing a smartphone as an OCT platform, although much work remains to be done before such a platform would be commercially viable.[97] Photonic integrated circuits may be a promising option to miniaturized OCT. Similarly to integrated circuits silicon-based fabrication techniques can be used to produced miniaturized photonic systems. First in vivo human retinal imaging has been reported recently [98]
See also
- Angle-resolved low-coherence interferometry
- Ballistic photon
- Confocal microscopy
- Interferometry
- Intracoronary optical coherence tomography
- Leica Microsystems
- Medical imaging
- Novacam Technologies
- Optical heterodyne detection
- Optical projection tomography
- Spectroscopic optical coherence tomography
- Terahertz tomography
- Tomography
References
- Bezerra HG, Costa MA, Guagliumi G, Rollins AM, Simon DI (November 2009). "Intracoronary optical coherence tomography: a comprehensive review clinical and research applications". JACC. Cardiovascular Interventions. 2 (11): 1035–1046. doi:10.1016/j.jcin.2009.06.019. PMC 4113036. PMID 19926041.
- Chua S (2015). "High-Definition Optical Coherence Tomography for the Study of Evolution of a Disease" (PDF). Dermatology Bulletin. 26 (1): 2–3. Retrieved 28 May 2015.
- Karnowski K, Ajduk A, Wieloch B, Tamborski S, Krawiec K, Wojtkowski M, Szkulmowski M (June 2017). "Optical coherence microscopy as a novel, non-invasive method for the 4D live imaging of early mammalian embryos". Scientific Reports. 7 (1): 4165. Bibcode:2017NatSR...7.4165K. doi:10.1038/s41598-017-04220-8. PMC 5482811. PMID 28646146.
- Zhu J, Freitas HR, Maezawa I, Jin LW, Srinivasan VJ (July 2021). "1700 nm optical coherence microscopy enables minimally invasive, label-free, in vivo optical biopsy deep in the mouse brain". Light, Science & Applications. 10 (1): 145. Bibcode:2021LSA....10..145Z. doi:10.1038/s41377-021-00586-7. PMC 8280201. PMID 34262015.
- Fercher AF, Roth E (15 September 1986). Mueller GJ (ed.). "Ophthalmic laser interferometry". Proc. SPIE. Optical Instrumentation for Biomedical Laser Applications. 658: 48–51. Bibcode:1986SPIE..658...48F. doi:10.1117/12.938523. S2CID 122883903.
- Fercher AF, Mengedoht K, Werner W (March 1988). "Eye-length measurement by interferometry with partially coherent light". Optics Letters. 13 (3): 186–8. Bibcode:1988OptL...13..186F. doi:10.1364/OL.13.000186. PMID 19742022.
- Fercher AF (12–16 August 1990). "Ophthalmic interferometry". In von Bally G, Khanna S (eds.). Proceedings of the International Conference on Optics in Life Sciences. Garmisch-Partenkirchen, Germany. pp. 221–228. ISBN 0-444-89860-3.
- Naohiro Tanno, Tsutomu Ichikawa, Akio Saeki: "Lightwave Reflection Measurement," Japanese Patent # 2010042 (1990) (Japanese Language)
- Shinji Chiba; Naohiro Tanno (1991). Backscattering Optical Heterodyne Tomography. 14th Laser Sensing Symposium (in Japanese).
- Huang D, Swanson EA, Lin CP, Schuman JS, Stinson WG, Chang W, et al. (November 1991). "Optical coherence tomography". Science. 254 (5035): 1178–81. Bibcode:1991Sci...254.1178H. doi:10.1126/science.1957169. PMC 4638169. PMID 1957169.
- Zysk AM, Nguyen FT, Oldenburg AL, Marks DL, Boppart SA (2007). "Optical coherence tomography: a review of clinical development from bench to bedside". Journal of Biomedical Optics. 12 (5): 051403. Bibcode:2007JBO....12e1403Z. doi:10.1117/1.2793736. PMID 17994864. S2CID 20621284.
- Fercher AF, Hitzenberger CK, Drexler W, Kamp G, Sattmann H (July 1993). "In vivo optical coherence tomography". American Journal of Ophthalmology. 116 (1): 113–4. doi:10.1016/S0002-9394(14)71762-3. PMID 8328536.
- Swanson EA, Izatt JA, Hee MR, Huang D, Lin CP, Schuman JS, et al. (November 1993). "In vivo retinal imaging by optical coherence tomography". Optics Letters. 18 (21): 1864–6. Bibcode:1993OptL...18.1864S. doi:10.1364/OL.18.001864. PMID 19829430. S2CID 21218566.
- Drexler W, Morgner U, Ghanta RK, Kärtner FX, Schuman JS, Fujimoto JG (April 2001). "Ultrahigh-resolution ophthalmic optical coherence tomography". Nature Medicine. 7 (4): 502–7. doi:10.1038/86589. PMC 1950821. PMID 11283681.
- Kaufman SC, Musch DC, Belin MW, Cohen EJ, Meisler DM, Reinhart WJ, et al. (February 2004). "Confocal microscopy: a report by the American Academy of Ophthalmology". Ophthalmology. 111 (2): 396–406. doi:10.1016/j.ophtha.2003.12.002. PMID 15019397.
- Riederer SJ (2000). "Current technical development of magnetic resonance imaging". IEEE Engineering in Medicine and Biology Magazine. 19 (5): 34–41. doi:10.1109/51.870229. PMID 11016028.
- M. Born; E. Wolf (2000). Principles of Optics: Electromagnetic Theory of Propagation, Interference, and Diffraction of Light. Cambridge University Press. ISBN 978-0-521-78449-8.
- Fujimoto JG, Pitris C, Boppart SA, Brezinski ME (2000). "Optical coherence tomography: an emerging technology for biomedical imaging and optical biopsy". Neoplasia. 2 (1–2): 9–25. doi:10.1038/sj.neo.7900071. PMC 1531864. PMID 10933065.
- Michelessi M, Lucenteforte E, Oddone F, Brazzelli M, Parravano M, Franchi S, et al. (November 2015). "Optic nerve head and fibre layer imaging for diagnosing glaucoma". The Cochrane Database of Systematic Reviews. 2020 (11): CD008803. doi:10.1002/14651858.CD008803.pub2. PMC 4732281. PMID 26618332.
- Drexler W, Morgner U, Kärtner FX, Pitris C, Boppart SA, Li XD, et al. (September 1999). "In vivo ultrahigh-resolution optical coherence tomography". Optics Letters. OSA. 24 (17): 1221–3. doi:10.1364/bio.1999.jwa2. PMID 18073990.
- "Optical Coherence Tomography provides better resolution than an MRI and Helps Diagnose Retina & Corneal Disease and Glaucoma, Part II". mastereyeassociates.com. mastereyeassociates. June 13, 2017. Retrieved June 13, 2017.
- Zhang, Hao F.; Beckmann, Lisa; Shu, Xiao (December 7, 2017). "Visible-light optical coherence tomography: a review". Journal of Biomedical Optics. spiedigitallibrary. 22 (12): 121707. Bibcode:2017JBO....22l1707S. doi:10.1117/1.JBO.22.12.121707. PMC 5745673. PMID 29218923.
- Garg A (2014). Anterior & Posterior Segment OCT: Current Technology & Future Applications, 1st edition.
- Schmitt JM (1999). "Optical coherence tomography (OCT): a review". IEEE Journal of Selected Topics in Quantum Electronics. 5 (4): 1205–1215. Bibcode:1999IJSTQ...5.1205S. doi:10.1109/2944.796348. S2CID 6102146.
- Fercher AF, Hitzenberger CK, Kamp G, El-Zaiat SY (1995). "Measurement of intraocular distances by backscattering spectral interferometry". Optics Communications. 117 (1–2): 43–48. Bibcode:1995OptCo.117...43F. doi:10.1016/0030-4018(95)00119-S.
- de Boer JF, Leitgeb R, Wojtkowski M (July 2017). "Twenty-five years of optical coherence tomography: the paradigm shift in sensitivity and speed provided by Fourier domain OCT [Invited]". Biomedical Optics Express. 8 (7): 3248–3280. doi:10.1364/BOE.8.003248. PMC 5508826. PMID 28717565.
- Beaurepaire E, Boccara AC, Lebec M, Blanchot L, Saint-Jalmes H (February 1998). "Full-field optical coherence microscopy". Optics Letters. 23 (4): 244–6. Bibcode:1998OptL...23..244B. doi:10.1364/ol.23.000244. PMID 18084473.
- Dubois A, Boccara C (October 2006). "[Full-field OCT]". Médecine/Sciences (in French). 22 (10): 859–64. doi:10.1051/medsci/20062210859. PMID 17026940.
- Dubois A, Moneron G, Boccara C (2006). "Thermal-light full-field optical coherence tomography in the 1.2 micron wavelength region" (PDF). Optics Communications. 266 (2): 738–743. Bibcode:2006OptCo.266..738D. doi:10.1016/j.optcom.2006.05.016.
- Boccara AC, Harms F, Latrive A (2013). "Full-field OCT: a non-invasive tool for diagnosis and tissue selection". SPIE Newsroom. doi:10.1117/2.1201306.004933. S2CID 123478275.
- Žurauskas M, Iyer RR, Boppart SA (February 2021). "Simultaneous 4-phase-shifted full-field optical coherence microscopy". Biomedical Optics Express. The Optical Society. 12 (2): 981–992. doi:10.1364/boe.417183. PMC 7901320. PMID 33680554.
- Boccara AC, Dubois A (2013). "Optical Coherence Tomography". Optics in Instruments. pp. 101–123. doi:10.1002/9781118574386.ch3. ISBN 9781118574386.
- Dubois A, Levecq O, Azimani H, Davis A, Ogien J, Siret D, Barut A (December 2018). "Line-field confocal time-domain optical coherence tomography with dynamic focusing". Optics Express. 26 (26): 33534–33542. Bibcode:2018OExpr..2633534D. doi:10.1364/OE.26.033534. PMID 30650800.
- Ogien, Jonas; Levecq, Olivier; Azimani, Hicham; Dubois, Arnaud; Dubois, Arnaud (2020-03-01). "Dual-mode line-field confocal optical coherence tomography for ultrahigh-resolution vertical and horizontal section imaging of human skin in vivo". Biomedical Optics Express. 11 (3): 1327–1335. doi:10.1364/BOE.385303. ISSN 2156-7085. PMC 7075601. PMID 32206413.
- Ogien, Jonas; Daures, Anthony; Cazalas, Maxime; Perrot, Jean-Luc; Dubois, Arnaud (2020-12-15). "Line-field confocal optical coherence tomography for three-dimensional skin imaging". Frontiers of Optoelectronics. 13 (4): 381–392. doi:10.1007/s12200-020-1096-x. ISSN 2095-2759. S2CID 234456595.
- Chen Y, Huang SW, Aguirre AD, Fujimoto JG (July 2007). "High-resolution line-scanning optical coherence microscopy". Optics Letters. 32 (14): 1971–3. Bibcode:2007OptL...32.1971C. doi:10.1364/OL.32.001971. PMID 17632613.
- Dubois A, Levecq O, Azimani H, Siret D, Barut A, Suppa M, et al. (October 2018). "Line-field confocal optical coherence tomography for high-resolution noninvasive imaging of skin tumors". Journal of Biomedical Optics. 23 (10): 106007. Bibcode:2018JBO....23j6007D. doi:10.1117/1.JBO.23.10.106007. PMID 30353716.
- Ruini, C.; Schuh, S.; Gust, C.; Kendziora, B.; Frommherz, L.; French, L. E.; Hartmann, D.; Welzel, J.; Sattler, E. (2021). "Line-field optical coherence tomography: in vivo diagnosis of basal cell carcinoma subtypes compared with histopathology". Clinical and Experimental Dermatology. 46 (8): 1471–1481. doi:10.1111/ced.14762. ISSN 1365-2230. PMID 34047380. S2CID 235232158.
- Suppa, M.; Fontaine, M.; Dejonckheere, G.; Cinotti, E.; Yélamos, O.; Diet, G.; Tognetti, L.; Miyamoto, M.; Cano, C. Orte; Perez-Anker, J.; Panagiotou, V. (2021). "Line-field confocal optical coherence tomography of basal cell carcinoma: a descriptive study". Journal of the European Academy of Dermatology and Venereology. 35 (5): 1099–1110. doi:10.1111/jdv.17078. ISSN 1468-3083. PMID 33398911. S2CID 230583854.
- Cinotti, E.; Tognetti, L.; Cartocci, A.; Lamberti, A.; Gherbassi, S.; Cano, C. Orte; Lenoir, C.; Dejonckheere, G.; Diet, G.; Fontaine, M.; Miyamoto, M. (2021). "Line-field confocal optical coherence tomography for actinic keratosis and squamous cell carcinoma: a descriptive study". Clinical and Experimental Dermatology. 46 (8): 1530–1541. doi:10.1111/ced.14801. ISSN 1365-2230. PMID 34115900. S2CID 235411841.
- Lenoir, C.; Cinotti, E.; Tognetti, L.; Cano, C. Orte; Diet, G.; Miyamoto, M.; Rocq, L.; Trépant, A.-L.; Perez-Anker, J.; Puig, S.; Malvehy, J. (2021). "Line-field confocal optical coherence tomography of actinic keratosis: a case series". Journal of the European Academy of Dermatology and Venereology. 35 (12): e900–e902. doi:10.1111/jdv.17548. ISSN 1468-3083. PMID 34310768. S2CID 236452537.
- Ruini, C.; Schuh, S.; Gust, C.; Kendziora, B.; Frommherz, L.; French, L. E.; Hartmann, D.; Welzel, J.; Sattler, E. C. (2021). "Line-field confocal optical coherence tomography for the in vivo real-time diagnosis of different stages of keratinocyte skin cancer: a preliminary study". Journal of the European Academy of Dermatology and Venereology. 35 (12): 2388–2397. doi:10.1111/jdv.17603. ISSN 1468-3083. PMID 34415646. S2CID 237241412.
- Pedrazzani M, Breugnot J, Rouaud-Tinguely P, Cazalas M, Davis A, Bordes S, et al. (May 2020). "Comparison of line-field confocal optical coherence tomography images with histological sections: Validation of a new method for in vivo and non-invasive quantification of superficial dermis thickness". Skin Research and Technology. 26 (3): 398–404. doi:10.1111/srt.12815. PMID 31799766. S2CID 208622348.
- Yeow JT, Yang VX, Chahwan A, Gordon ML, Qi B, Vitkin IA, Wilson BC, Goldenberg AA (2005). "Micromachined 2-D scanner for 3-D optical coherence tomography". Sensors and Actuators A: Physical. 117 (2): 331–340. doi:10.1016/j.sna.2004.06.021.
- Dunsby C, Gu Y, French P (January 2003). "Single-shot phase-stepped wide-field coherencegated imaging". Optics Express. 11 (2): 105–15. Bibcode:2003OExpr..11..105D. doi:10.1364/OE.11.000105. PMID 19461712.
- Roy M, Svahn P, Cherel L, Sheppard CJ (2002). "Geometric phase-shifting for low-coherence interference microscopy". Optics and Lasers in Engineering. 37 (6): 631–641. Bibcode:2002OptLE..37..631R. doi:10.1016/S0143-8166(01)00146-4.
- Akiba M, Chan KP, Tanno N (May 2003). "Full-field optical coherence tomography by two-dimensional heterodyne detection with a pair of CCD cameras". Optics Letters. 28 (10): 816–8. Bibcode:2003OptL...28..816A. doi:10.1364/OL.28.000816. PMID 12779156.
- Dubois A, Vabre L, Boccara AC, Beaurepaire E (February 2002). "High-resolution full-field optical coherence tomography with a Linnik microscope". Applied Optics. 41 (4): 805–12. Bibcode:2002ApOpt..41..805D. doi:10.1364/AO.41.000805. PMID 11993929.
- Bourquin S, Seitz P, Salathé RP (April 2001). "Optical coherence topography based on a two-dimensional smart detector array". Optics Letters. 26 (8): 512–4. Bibcode:2001OptL...26..512B. doi:10.1364/OL.26.000512. PMID 18040369.
- "The ABCs of OCT". Review of Optometry.
- Sherman J (June 2009). "Photoreceptor integrity line joins the nerve fiber layer as key to clinical diagnosis". Optometry. 80 (6): 277–8. doi:10.1016/j.optm.2008.12.006. PMID 19465337.
- "Outer Retinal Layers as Predictors of Vision Loss". Review of Ophthalmology.
- Cuenca N, Ortuño-Lizarán I, Pinilla I (March 2018). "Cellular Characterization of OCT and Outer Retinal Bands Using Specific Immunohistochemistry Markers and Clinical Implications". Ophthalmology. 125 (3): 407–422. doi:10.1016/j.ophtha.2017.09.016. hdl:10045/74474. PMID 29037595.
- Grewal DS, Tanna AP (March 2013). "Diagnosis of glaucoma and detection of glaucoma progression using spectral domain optical coherence tomography". Current Opinion in Ophthalmology. 24 (2): 150–61. doi:10.1097/ICU.0b013e32835d9e27. PMID 23328662. S2CID 39039199.
- Keane PA, Patel PJ, Liakopoulos S, Heussen FM, Sadda SR, Tufail A (September 2012). "Evaluation of age-related macular degeneration with optical coherence tomography". Survey of Ophthalmology. 57 (5): 389–414. doi:10.1016/j.survophthal.2012.01.006. PMID 22898648.
- Virgili G, Menchini F, Casazza G, Hogg R, Das RR, Wang X, Michelessi M (January 2015). "Optical coherence tomography (OCT) for detection of macular oedema in patients with diabetic retinopathy". The Cochrane Database of Systematic Reviews. 1: CD008081. doi:10.1002/14651858.CD008081.pub3. PMC 4438571. PMID 25564068.
- Dörr J, Wernecke KD, Bock M, Gaede G, Wuerfel JT, Pfueller CF, et al. (April 2011). "Association of retinal and macular damage with brain atrophy in multiple sclerosis". PLOS ONE. 6 (4): e18132. Bibcode:2011PLoSO...618132D. doi:10.1371/journal.pone.0018132. PMC 3072966. PMID 21494659.

- Aik Kah T (2018). "CuRRL Syndrome: A Case Series" (PDF). Acta Scientific Ophthalmology. 1: 9–13.
- Kashani AH, Chen CL, Gahm JK, Zheng F, Richter GM, Rosenfeld PJ, et al. (September 2017). "Optical coherence tomography angiography: A comprehensive review of current methods and clinical applications". Progress in Retinal and Eye Research. 60: 66–100. doi:10.1016/j.preteyeres.2017.07.002. PMC 5600872. PMID 28760677.
- Ehlers JP, Tao YK, Srivastava SK (May 2014). "The value of intraoperative optical coherence tomography imaging in vitreoretinal surgery". Current Opinion in Ophthalmology. 25 (3): 221–227. doi:10.1097/ICU.0000000000000044. PMC 4119822. PMID 24614147.
- Pfau M, Michels S, Binder S, Becker MD (2015). "Clinical Experience With the First Commercially Available Intraoperative Optical Coherence Tomography System". Ophthalmic Surg Lasers Imaging Retina. 46 (10): 1001–8. doi:10.3928/23258160-20151027-03. PMID 26599241.
- Neuhann R, Neuhann T, Hörster R, Cursiefen C, Guell J, Siebelmann S (August 2021). "Laser-integrated Real-Time Optical Coherence Tomography (LI-OCT) in Anterior Segment Procedures". J Cataract Refract Surg. 47 (12): e88–e92. doi:10.1097/j.jcrs.0000000000000773. PMID 34393183.
- Neuhann R, Neuhann T, Hörster R, Cursiefen C, Guell J, Siebelmann S (December 2021). "Laser-integrated real-time OCT in anterior segment procedures". Journal of Cataract and Refractive Surgery. 47 (12): e88–e92. doi:10.1364/BOE.426079. PMC 8367251. PMID 34393183.
- Tearney GJ, Brezinski ME, Bouma BE, Boppart SA, Pitris C, Southern JF, Fujimoto JG (June 1997). "In vivo endoscopic optical biopsy with optical coherence tomography". Science. 276 (5321): 2037–9. doi:10.1126/science.276.5321.2037. PMID 9197265. S2CID 43035300.
- Tearney GJ, Waxman S, Shishkov M, Vakoc BJ, Suter MJ, Freilich MI, et al. (November 2008). "Three-dimensional coronary artery microscopy by intracoronary optical frequency domain imaging". JACC. Cardiovascular Imaging. 1 (6): 752–61. doi:10.1016/j.jcmg.2008.06.007. PMC 2852244. PMID 19356512.
- "LightLab launches FD-OCT in Europe". Retrieved 9 September 2016.
- Swanson E (13 June 2016). "Optical Coherence Tomography: Beyond better clinical care: OCT's economic impact". BioOptics World. Retrieved 9 September 2016.
- Chen CJ, Kumar JS, Chen SH, Ding D, Buell TJ, Sur S, et al. (April 2018). "Optical Coherence Tomography: Future Applications in Cerebrovascular Imaging". Stroke. 49 (4): 1044–1050. doi:10.1161/STROKEAHA.117.019818. PMID 29491139.
- Xu X, Li M, Liu R, Yin Q, Shi X, Wang F, et al. (August 2020). "Optical coherence tomography evaluation of vertebrobasilar artery stenosis: case series and literature review". Journal of NeuroInterventional Surgery. 12 (8): 809–813. doi:10.1136/neurintsurg-2019-015660. PMID 32066569. S2CID 211159079.
- Ughi GJ, Marosfoi MG, King RM, Caroff J, Peterson LM, Duncan BH, et al. (July 2020). "A neurovascular high-frequency optical coherence tomography system enables in situ cerebrovascular volumetric microscopy". Nature Communications. 11 (1): 3851. Bibcode:2020NatCo..11.3851U. doi:10.1038/s41467-020-17702-7. PMC 7395105. PMID 32737314.
- Ughi GJ, Wang H, Gerbaud E, Gardecki JA, Fard AM, Hamidi E, et al. (November 2016). "Clinical Characterization of CoronaryAtherosclerosis With Dual-Modality OCTand Near-Infrared Autofluorescence Imaging". JACC. Cardiovascular Imaging. 9 (11): 1304–1314. doi:10.1016/j.jcmg.2015.11.020. PMC 5010789. PMID 26971006.
- "Next-gen OCT for the esophagus". BioOptics World. 1 May 2013. Retrieved 9 September 2016.
- Welzel J, Lankenau E, Birngruber R, Engelhardt R (December 1997). "Optical coherence tomography of the human skin" (PDF). Journal of the American Academy of Dermatology. 37 (6): 958–63. doi:10.1016/S0190-9622(97)70072-0. PMID 9418764.
- Boone MA, Norrenberg S, Jemec GB, Del Marmol V (October 2012). "Imaging of basal cell carcinoma by high-definition optical coherence tomography: histomorphological correlation. A pilot study". The British Journal of Dermatology. 167 (4): 856–64. doi:10.1111/j.1365-2133.2012.11194.x. PMID 22862425. S2CID 24965088.
- Coleman AJ, Richardson TJ, Orchard G, Uddin A, Choi MJ, Lacy KE (February 2013). "Histological correlates of optical coherence tomography in non-melanoma skin cancer". Skin Research and Technology. 19 (1): 10–9. doi:10.1111/j.1600-0846.2012.00626.x. PMID 22738357. S2CID 26084419.
- Ulrich M, von Braunmuehl T, Kurzen H, Dirschka T, Kellner C, Sattler E, et al. (August 2015). "The sensitivity and specificity of optical coherence tomography for the assisted diagnosis of nonpigmented basal cell carcinoma: an observational study". The British Journal of Dermatology. 173 (2): 428–35. doi:10.1111/bjd.13853. PMID 25904111.
- Levine A, Wang K, Markowitz O (October 2017). "Optical Coherence Tomography in the Diagnosis of Skin Cancer". Dermatologic Clinics. 35 (4): 465–488. doi:10.1016/j.det.2017.06.008. PMID 28886803.
- Dubois A, Levecq O, Azimani H, Siret D, Barut A, Suppa M, et al. (October 2018). "Line-field confocal optical coherence tomography for high-resolution noninvasive imaging of skin tumors" (PDF). Journal of Biomedical Optics. 23 (10): 106007. Bibcode:2018JBO....23j6007D. doi:10.1117/1.JBO.23.10.106007. PMID 30353716. S2CID 53023955.
This article contains quotations from this source, which is available under the Creative Commons Attribution 3.0 Unported (CC BY 3.0) license. - Velusamy P, Shimada Y, Kanno Z, Ono T, Tagami J (February 2019). "Optical evaluation of enamel white spot lesions around orthodontic brackets using swept-source optical coherence tomography (SS-OCT): An in vitro study". Dental Materials Journal. 38 (1): 22–27. doi:10.4012/dmj.2017-262. PMID 30158348.
- Damestani Y, Reynolds CL, Szu J, Hsu MS, Kodera Y, Binder DK, et al. (November 2013). "Transparent nanocrystalline yttria-stabilized-zirconia calvarium prosthesis". Nanomedicine. 9 (8): 1135–8. doi:10.1016/j.nano.2013.08.002. PMID 23969102. Lay summary – Los Angeles Times (September 4, 2013).
{{cite journal}}: Cite uses deprecated parameter|lay-source=(help) - B1 US patent 7116429 B1, Walecki WJ = Van P, "Determining thickness of slabs of materials", issued 2006-10-03.
- Walecki WJ, Szondy F (2008). Novak EL, Wolfgang O, Gorecki C (eds.). "Integrated quantum efficiency, reflectance, topography and stress metrology for solar cell manufacturing". Proc. SPIE. Interferometry XIV: Applications. 7064: 70640A. Bibcode:2008SPIE.7064E..0AW. doi:10.1117/12.797541. S2CID 120257179.
- Walecki WJ, Lai K, Pravdivtsev A, Souchkov V, Van P, Azfar T, Wong T, Lau SH, Koo A (2005). Tanner DM, Ramesham R (eds.). "Low-coherence interferometric absolute distance gauge for study of MEMS structures". Proc. SPIE. Reliability, Packaging, Testing, and Characterization of MEMS/MOEMS IV. 5716: 182. Bibcode:2005SPIE.5716..182W. doi:10.1117/12.590013. S2CID 110785119.
- Walecki WJ, Lai K, Souchkov V, Van P, Lau SH, Koo A (2005). "Novel noncontact thickness metrology for backend manufacturing of wide bandgap light emitting devices". Physica Status Solidi C. 2 (3): 984–989. Bibcode:2005PSSCR...2..984W. doi:10.1002/pssc.200460606.
- Walecki W, Wei F, Van P, Lai K, Lee T, Lau SH, Koo A (2004). Tanner DM, Rajeshuni R (eds.). "Novel low coherence metrology for nondestructive characterization of high-aspect-ratio microfabricated and micromachined structures". Proc. SPIE. Reliability, Testing, and Characterization of MEMS/MOEMS III. 5343: 55. doi:10.1117/12.530749. S2CID 123249666.
- Guss G, Bass I, Hackel R, Demos SG (November 6, 2007). High-resolution 3-D imaging of surface damage sites in fused silica with Optical Coherence Tomography (PDF) (Report). Lawrence Livermore National Laboratory. UCRL-PROC-236270. Archived from the original (PDF) on February 11, 2017. Retrieved December 14, 2010.
- Walecki W, Wei F, Van P, Lai K, Lee T, Lau SH, Koo A (2004). Interferometric Metrology for Thin and Ultra-Thin Compound Semiconductor Structures Mounted on Insulating Carriers (PDF). CS Mantech Conference.
- Walecki WJ, Pravdivtsev A, Santos II M, Koo A (August 2006). "High-speed high-accuracy fiber optic low-coherence interferometry for in situ grinding and etching process monitoring". Proc. SPIE. Interferometry XIII: Applications. 6293: 62930D. Bibcode:2006SPIE.6293E..0DW. doi:10.1117/12.675592. S2CID 121209439.
- See, for example: "ZebraOptical Optoprofiler: Interferometric Probe".
- EP application 2799842, Markl, Daniel; Hannesschläger, Günther & Leitner, Michael et al., "A device and a method for monitoring a property of a coating of a solid dosage form during a coating process forming the coating of the solid dosage form", published 2014-11-05; GB application 2513581; US application 20140322429 A1.
- Walecki WJ, Szondy F, Wang A (30 April 2009). Xiao H, Fan S (eds.). "Fiber optics low-coherence IR interferometry for defense sensors manufacturing" (PDF). Proc. SPIE. Photonic Microdevices/Microstructures for Sensing. 7322: 73220K. Bibcode:2009SPIE.7322E..0KW. doi:10.1117/12.818381. S2CID 120168355.
- Dufour M, Lamouche G, Gauthier B, Padioleau C, Monchalin JP (13 December 2006). "Inspection of hard-to-reach industrial parts using small diameter probes" (PDF). SPIE Newsroom. doi:10.1117/2.1200610.0467. Retrieved December 15, 2010.
- Dufour ML, Lamouche G, Detalle V, Gauthier B, Sammut P (April 2005). "Low-Coherence Interferometry, an Advanced Technique for Optical Metrology in Industry". Insight: Non-Destructive Testing and Condition Monitoring. 47 (4): 216–219. CiteSeerX 10.1.1.159.5249. doi:10.1784/insi.47.4.216.63149. ISSN 1354-2575.
- Boppart S (11 June 2014). "Developing new optical imaging techniques for clinical use". SPIE Newsroom. doi:10.1117/2.3201406.03.
- Al-Azri K, Melita LN, Strange AP, Festy F, Al-Jawad M, Cook R, et al. (March 2016). "Optical coherence tomography use in the diagnosis of enamel defects". Journal of Biomedical Optics. 21 (3): 36004. Bibcode:2016JBO....21c6004A. doi:10.1117/1.jbo.21.3.036004. PMID 26968386.
- Iino Y, Ebihara A, Yoshioka T, Kawamura J, Watanabe S, Hanada T, et al. (November 2014). "Detection of a second mesiobuccal canal in maxillary molars by swept-source optical coherence tomography". Journal of Endodontics. 40 (11): 1865–8. doi:10.1016/j.joen.2014.07.012. PMID 25266471.
- Subhash HM, Hogan JN, Leahy MJ (May 2015). "Multiple-reference optical coherence tomography for smartphone applications". SPIE Newsroom. doi:10.1117/2.1201503.005807.
- Rank EA, Sentosa R, Harper DJ, Salas M, Gaugutz A, Seyringer D, et al. (January 2021). "Toward optical coherence tomography on a chip: in vivo three-dimensional human retinal imaging using photonic integrated circuit-based arrayed waveguide gratings". Light, Science & Applications. 10 (1): 6. Bibcode:2021LSA....10....6R. doi:10.1038/s41377-020-00450-0. PMC 7785745. PMID 33402664.




